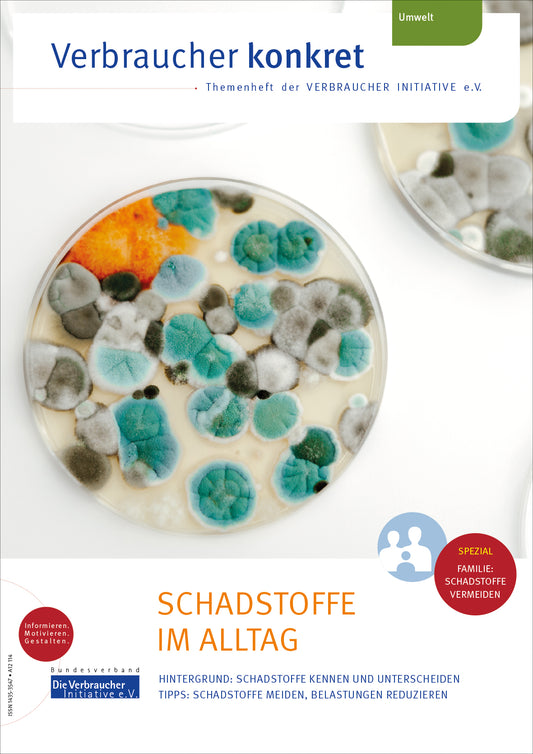
Schadstoffe im Alltag

Kategorie: Nachhaltigkeit
-
Verpackungsflut? - Nachhaltig entscheiden!
Normaler Preis Von €1,00 EURNormaler Preis -
Kleingarten? Großartig!
Normaler Preis Von €1,00 EURNormaler Preis -
Tierhaltung im Wandel
Normaler Preis Von €1,00 EURNormaler Preis -
Reisen bewusst genießen
Normaler Preis Von €1,00 EURNormaler Preis -
Kleidung clever nutzen
Normaler Preis €0,00 EURNormaler Preis -
Klimaanpassung (für) Zuhause
Normaler Preis €0,00 EURNormaler Preis -
Generation 55+ und Labels
Normaler Preis Von €1,00 EURNormaler Preis -
Nachhaltig feiern & schenken
Normaler Preis Von €1,00 EURNormaler Preis -
Besonders sparsame Haushaltsgeräte
Normaler Preis €0,00 EURNormaler Preis -
Nachhaltig digital konsumieren
Normaler Preis Von €1,00 EURNormaler Preis -
Nachhaltig in der Freizeit
Normaler Preis Von €1,00 EURNormaler Preis -
Holz & Papier
Normaler Preis Von €1,00 EURNormaler Preis -
Schadstoffe im Alltag
Normaler Preis Von €1,00 EURNormaler Preis -
Abfall richtig entsorgen
Normaler Preis Von €1,00 EURNormaler Preis -
Clever Energie sparen
Normaler Preis €1,00 EURNormaler Preis -
Klimafreundlich mobil
Normaler Preis €1,00 EURNormaler Preis